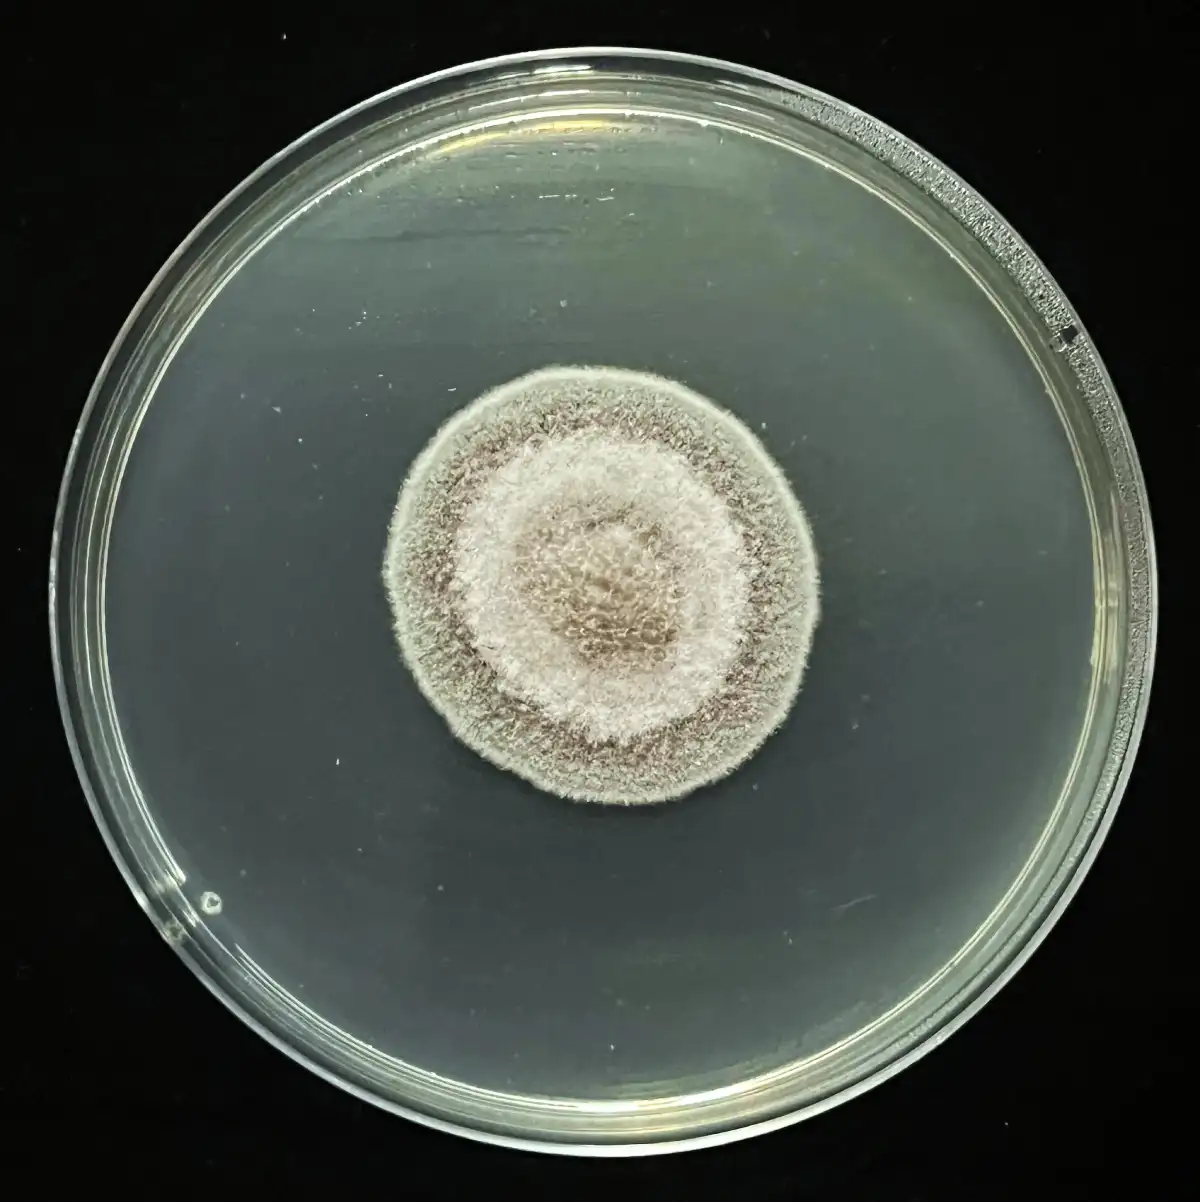

QUIÉNES SOMOS Y CÓMO TRABAJAMOS
En CMBIO desarrollamos servicios especializados de diagnóstico e investigación aplicada al sector agrícola, orientados a comprender y resolver problemas fitosanitarios que afectan la productividad de los cultivos.
Nuestro trabajo combina evaluación en campo, análisis de laboratorio y conocimiento científico, permitiendo generar información confiable para la toma de decisiones técnicas en empresas agrícolas, agroexportadoras y compañías del sector de agroinsumos.
Enfoque técnico-científico
Nuestro trabajo se fundamenta en metodologías científicas y protocolos de diagnóstico que garantizan resultados confiables. Aplicamos herramientas de análisis, identificación de plagas y enfermedades, y evaluación de factores agronómicos para comprender de manera precisa los problemas que afectan a los cultivos.
Trabajo en campo y laboratorio
Integramos evaluaciones directas en campo con análisis especializados en laboratorio. Esta combinación permite obtener diagnósticos precisos sobre plagas, patógenos y otros factores que influyen en la sanidad y productividad agrícola, generando información clave para el manejo técnico de los cultivos.
Investigación aplicada al sector agrícola
Desarrollamos estudios y evaluaciones orientados a resolver desafíos reales del sector agrícola. Nuestro enfoque de investigación aplicada transforma los resultados de análisis y diagnósticos en soluciones técnicas que contribuyen a mejorar la sanidad vegetal, optimizar la productividad y fortalecer el manejo sostenible de los cultivos.
Soporte técnico para el desarrollo y validación de tecnologías agrícolas.
Generamos información técnica confiable en condiciones reales de campo, contribuyendo al desarrollo, posicionamiento y mejora de tecnologías para la sanidad y productividad agrícola.